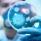
الصحة الأردنية تنفي إحالة 37 شخصا للحجر الصحي بسبب كورونا

منذ 6 سنوات
اليابان تسجل أول وفاة بفيروس كورونا

حجم الخط
شبكة وتر-أكد وزير الصحة الياباني كاتسونوبو كاتو، أن بلاده شهدت اليوم الخميس، أول حالة وفاة بفيروس كورونا الجديد.
وأعلن في مؤتمر صحفي عقده اليوم، أن امرأة في الثمانين من عمرها تعيش في ولاية كاناغاوا المجاورة لطوكيو توفيت بسبب إصابتها بهذا الفيروس.
كما سبق للسلطات اليابانية وأعلنت مؤخرا عن تسجيل أول وفاة بين اليابانيين المقيمين في مدينة ووهان الصينية بفيروس كورونا.
وأعلنت وزارة الخارجية اليابانية السبت وفاة رجل ياباني كان قد نقل إلى المستشفى مصابا بالتهاب رئوي في مدينة ووهان الصينية بؤرة تفشي فيروس كورونا.